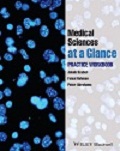

- Home
- Multiple Choice
- Key points
- Your Feedback
- Become a reviewer
- ‘At a Glance’ series
- Wiley student books
- Student Apps
- Join an e-mail list


Welcome to the companion resources site for Medical Sciences at a Glance.
On this site you will find:
There is a Practice Workbook to accompany this title - available separately:
Buy/find out more |
Medical Sciences at a Glance: Practice Workbook Jakub Scaber, Peter Abrahams & Faisal Rahman
|